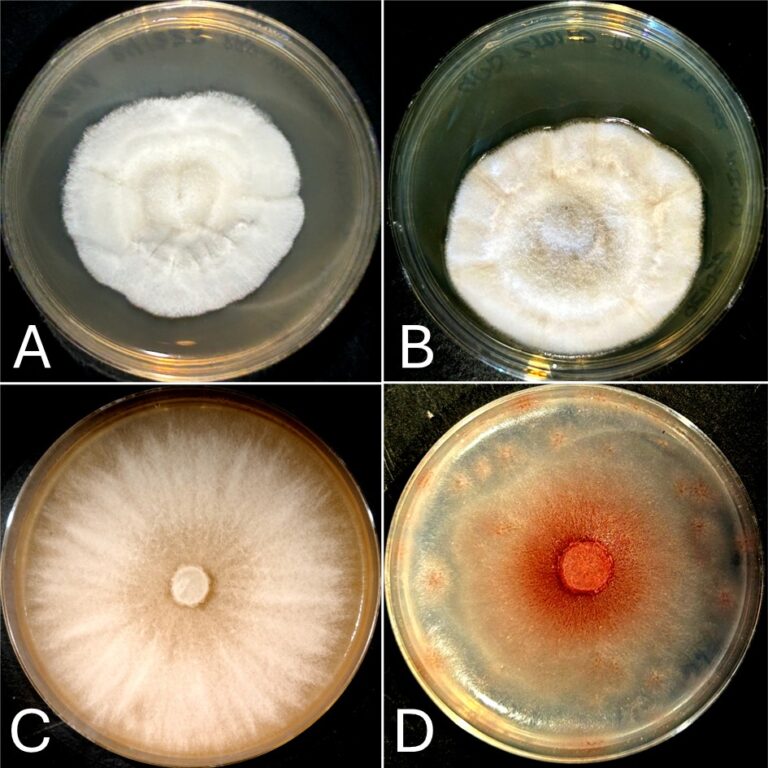
Masquerading molds – The importance of genotyping for fungal identification

Masquerading molds – The importance of genotyping for fungal identification
We all know that we can’t trust everything we see online. But fungi have been faking their appearance since long before the internet. Microorganisms, and other living things, can be identified and characterized based on two attributes, their genotype and their phenotype. When reporting a phenotypic description, we are reporting observable characteristics of the organism…